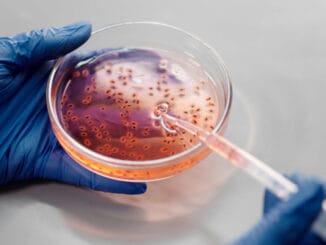

Afrika ve Güney Amerika arasında Güneydoğu Anadolu bölgesi büyüklüğünde dev bir yosun tarlasının yüzdüğünü hayal edin.
Okyanusta doğal bir şekilde süzülürken her yıl atmosferden milyarlarca ton karbonu emerek zararsız bir şekilde denizin dibine gönderiyor.
Kulağa fantastik mi geliyor? Belki… Ama bir İngiliz işadamı bunu 2026’ya kadar hayata geçirmeyi planlıyor.
Bilim insanları küresel karbon salımını azaltmanın iklim değişikliğiyle mücadele için yeterli olmayacağını, bu nedenle atmosferden karbon çeken yöntemlerin geliştirilmesinin hayati öneme sahip olduğunu söylüyor.
Fakat atmosferden karbon çekmek için denenen yöntemler bugüne kadar hep küçük çaplı kaldı ve başarısı da aynı oranda sınırlı oldu.
Bu yöntemlerin işe yaraması için iddialı, büyük ve yatırımcılar için cazip olması gerekiyor.
İngiliz işadamı John Auckland’ın Seafields projesi sadece atmosferdeki karbonu okyanus tabanına göndermeyi hedeflemiyor, aynı zamanda bu faaliyetle elde edeceği karbon kredisini diğer şirketlere satarak para kazanmayı da amaçlıyor.
55 bin kilometrekarelik bir alana yayılması planlanan bu dev yosun tarlası, başarılı olursa her yıl atmosferden bir milyar ton karbon çekecek.
Dünya çapında atmosfere 50 milyar ton karbon salındığı tahmin ediliyor.
Yani bu proje salınan karbonun yüzde 2’sini tek başına atmosferden geri alabilecek.
Deniz biyoloğu Victor Smetacek’in fikirlerinden ilham alan bu proje şimdi Karayipler’de ve Meksika’da test ediliyor.
Seafields’ın Bilimsel Kurucu sıfatını verdiği Prof. Smetacek, yosunların denizlerdeki dairesel akıntıların ortasında büyüme potansiyelinin kendisini şaşkınlığa düşürdüğünü söylüyor:
“Bu döngüsel akıntılar her şeyi merkezlerinde topluyor.
“Bugüne kadar daha çok okyanuslardaki dev plastik çöp adalarına yol açmalarıyla ünlenmişlerdi.”
John Auckland, bu akıntıların aynı şekilde yosunları da dağılmadan bir arada tutabileceğini anlatıyor, bir şekilde tarladan uzaklaşan yosunların da beslenemedikleri için öleceğini belirtiyor.
Haklı olsa iyi olur.
Çünkü kıyıya vurunca pis bir koku yayan bu yosun türü yıllardır Karayipler’deki turizme zarar veriyor.
Seafields ekibi, tarla için gerekli besinleri okyanusun daha alt kesimlerinden ince borularla yukarı taşımayı hedefliyor.
Tropik bölgelerde güneş ışınları daha kuvvetli olduğu için deniz suyu daha çok buharlaşıyor ve bu yüzden denizin üst katmanları çok tuzlu ve besinsiz oluyor. Bu yüzden buralara “okyanusların çölü” deniyor.
Altlarında ise besin açısından zengin olan su tabakası bulunuyor. Prof. Smetacek’in planı enerji kullanımı gerektirmeyecek bir devridaim sistemiyle aşağıdaki soğuk ve besleyici suyun yukarı çıkmasını, burada ısındıktan sonra da tekrar aşağı gönderilmesini sağlamak.
Bu devridaim sisteminin ilk deneyleri 2023’te başlayacak. Planın en kritik aşaması bu olduğu için o ana kadar gerilim yüksek olacak.
İlk olarak 1956’da teorik olarak bahsedilen bu yöntem, ilerleyen yıllarda pratikte de hayata geçirildi. Fakat bunların hiçbiri Seafields boyutlarında değildi.
Bu yöntem başarılı olursa sargassum yosunu hızla çoğalabilir. Prof. Smetacek “İnanılmaz bir büyüme hızları var. 10 günde bir kütleleri ikiye katlanıyor” diyor.
Planlara göre otomatik balya sistemleri büyüyen yosunları balyalayacak ve okyanus tabanına yollayacak.
Orada oksijen miktarı çok düşük olduğu için bu balyalar çürümeyecek ve içlerindeki karbon yüzlerce, belki de binler yıl atmosfere geri karışmayacak.
Seafields’ın finansörleri bunun sadece atmosfer için değil, banka hesapları için de kârlı olmasını umuyor.
Planları, deniz tabanına gönderilen karbon miktarı kadar, şirketlere karbon salım hakkı satmak.
Havayolları gibi karbon salımını azaltması çok zor olan şirketler, yükümlülüklerini yerine getirebilmek için bu tür krediler satın alıyor.
Karbon piyasasını eleştirenlerse bu motivasyonla hareket eden şirketlerin abartılı vaatlerle gelip bunları yerine getiremediğine dikkat çekiyor.
Bu da bizi başlangıç noktamıza geri götürüyor: Seafields’ın laboratuvarda umut vadeden bu planı okyanusun ortasında da işler mi?
East Anglia Üniversitesi’nde iklim değişikliği üzerine çalışan akademisyen Dr. Nem Vaughan “Ben sıkıcı bir bilim kadınıyım. Milyarlarca ton karbonun atmosferden gerçekten çekilebileceğini söylemeden önce daha fazla veri ve daha fazla araştırma görmek isterim” diyor.
Dr. Vaughan bu yöntemin biyolojik sistemler üzerinde büyük etkisi olmasından endişe duyuyor.
Seafields Güney Atlantik’e büyük zarar verebilecek bu yosun kütlesini güvenli bir şekilde ihtiva edebilir mi? Devridaim sistemi fırtınalardan sağ çıkabilir mi?
Vaughan “Büyük bir fırtınanın ardından kıyılara tonlarca plastik borunun vurması kimseyi mutlu etmez” diyor.
Küresel ısınmayla mücadele etmenin teknolojik açıdan daha basit yolları da var. Örneğin daha fazla ağaç ekmek, karbonu doğal olarak tutan turbalıklar gibi bölgeleri korumak ve Dr. Vaughan’a göre hepsinden önemlisi de “Karbonu atmosfere salmamak”:
“Fosil yakıtları çıkarmayı bırakın. Karbonu atmosfere salmamak, saldıktan sonra geri yakalayıp yere indirmeye çalışmaktan çok ama çok daha kolay.”
John Auckland da iş planlarının bazı parçalarının henüz test edilmemiş unsurlar içerdiğini kabul etse de bunun denemeye değer olduğunu düşünüyor:
“Her gün yatırımcıların daha riskli şeylere para yatırdığını görüyorum.
“İklim krizini çözerek büyük kârlar elde edebiliriz.
“Bunu riskli diyerek bir kenara itemeyiz. Herkes böyle düşünürse bu büyüklükteki bir çözüm yöntemi üzerine kimse çalışmaz.”

İlk yorum yapan olun